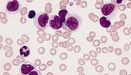

Силиконовые имплантаты связаны с повышенным риском некоторых заболеваний
Женщины, получающие силиконовые имплантаты, подвергались повышенному риску заболеваний по сравнению с другими жещинами.
Стадия развития опухоли глаза № 1 у детей
Хотя редко, ретинобластома является наиболее распространенной злокачественной опухолью глаза у детей и может привести к разрушительной потере зрения.
Raman – новый метод обнаружения раковых клеток
Радикальная, новая технология визуализации в хирургии рака.
Новое исследование пролило свет на 100-летнюю загадку рака
Новое исследование поможет идентифицировать «слабые места» раковых клеток меланомы и потенциальные терапевтические мишени.
Профилактика рака молочной железы не снижает смертность
Для женщины не всегда полезно диагностировать крошечный раковый рост, например, миллиметр в диаметре при маммографии.
Анализ белка открыл новые подтипы медуллобластомы
Ученые изучили модификации белка в медуллобластоме.
ДНК тест для прогнозирования риска рецидива лейкемии
Результаты исследования могут помочь врачам улучшить результат пациента, изменив лечение до того, как рак вернется в полную силу.
ЗАЯВКА НА ЛЕЧЕНИЕ
Отправляя форму Вы соглашаетесь с политикой конфиденциальности

Комментарии
Пока комментариев нет
Новый комментарий